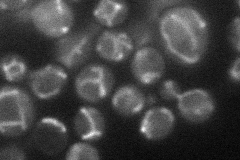
YNL083W
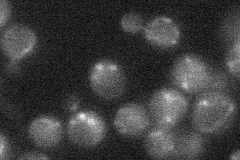
YNL083W
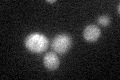
YNL083W

View description
ADP/ATP transporter; member of the Ca2+-binding subfamily of the mitochondrial carrier family, with two EF-hand motifs; Pet9p and Sal1p have an overlapping function critical for viability; polymorphic in different S. cerevisiae strains
Localization:
Intensity:
Fold change:
Significance:
-
C’ GFP library in SD

mitochondria18.48 -
N' NOP1pr-GFP in SD
mitochondria33.435 -
N' TEF2pr-mCherry in SD

mitochondria10.6784 -
N' NATIVEpr-GFP in SD
below threshold21.1531 -
N' TEF2pr-VC and Cyto-VN in SD

missing0 -
C’ GFP library in SD+DTT
mitochondria16.850.91No -
C’ GFP library in SD+H2O2

mitochondria17.760.96No -
C’ GFP library in Starvation Media

mitochondria15.440.83No -
C’ GFP library on the background of Pup2-DaMP

mitochondria -
C’ GFP library on the background of CCT mutant

mitochondria17.52920.947899No
